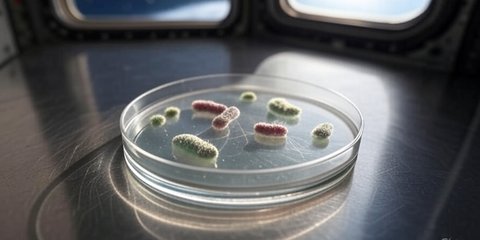
{{caption}}

China Temukan Cara Bikin Bahan Bakar Roket di Luar Angkasa, Begini Caranya!
Astronot China mengembangkan teknologi "fotosintesis buatan" di Stasiun Luar Angkasa Tiangong untuk menghasilkan bahan bakar roket.

Astronot China yang bertugas di Stasiun Luar Angkasa Tiangong berhasil menciptakan bahan bakar roket dengan metode inovatif yang mereka sebut "fotosintesis buatan."
Teknologi ini memungkinkan mereka mengubah karbon dioksida dan air menjadi oksigen dan etilena, senyawa hidrokarbon yang biasa digunakan sebagai bahan bakar roket.
Menurut laporan South China Morning Post (SCMP) dikutip dari Futurism, Senin (3/2), para astronot menggunakan katalis semikonduktor untuk meniru proses fotosintesis alami yang terjadi pada tumbuhan, tetapi dengan teknik rekayasa fisika dan kimia yang lebih canggih.
"Teknologi ini memanfaatkan sumber daya karbon dioksida di lingkungan luar angkasa untuk menghasilkan oksigen dan bahan bakar berbasis karbon," ungkap laporan dari CCTV, media pemerintah China.
Jika metode ini terbukti efektif, maka akan menjadi terobosan besar bagi eksplorasi luar angkasa, khususnya dalam misi jangka panjang ke Bulan dan Mars.
Keunggulan Dibanding Metode Konvensional
Selama ini, Stasiun Luar Angkasa Internasional (ISS) menghasilkan oksigen menggunakan metode elektrolisis air, yang menggunakan energi matahari untuk memecah air menjadi oksigen dan hidrogen. Namun, metode ini tergolong boros energi, sehingga tidak cocok untuk perjalanan antariksa jarak jauh.
Sebaliknya, teknologi fotosintesis buatan ini lebih hemat energi, karena proses konversi karbon dioksida dapat dilakukan pada suhu ruang dan tekanan atmosfer standar.
Masa Depan Eksplorasi Luar Angkasa
China telah menetapkan target ambisius untuk membangun pangkalan di kutub selatan Bulan pada 2035. Untuk mewujudkan hal ini, dibutuhkan sumber oksigen dan bahan bakar roket yang berkelanjutan agar astronot dapat bertahan hidup dan kembali ke Bumi dengan aman.
Meski hasil eksperimen ini masih perlu dikaji lebih lanjut, jika terbukti berhasil, China akan memimpin inovasi teknologi luar angkasa dan membuka era baru dalam eksplorasi planet lain.

























:strip_icc():format(webp)/kly-media-production/medias/8264184/original/044577600_1782097873-148737.jpg)
:strip_icc():format(webp)/kly-media-production/medias/8264140/original/056562800_1782095686-148744.jpg)
:strip_icc():format(webp)/kly-media-production/medias/5387645/original/081425400_1761087072-Mobil_ambulans.jpeg)
:strip_icc():format(webp)/kly-media-production/medias/8264116/original/061469400_1782093167-InShot_20260622_072802446.jpg)
:strip_icc():format(webp)/kly-media-production/medias/8264100/original/084587400_1782091519-IMG-20260622-WA0008.jpg)
:strip_icc():format(webp)/kly-media-production/medias/8264093/original/023191700_1782089867-148677.jpg)